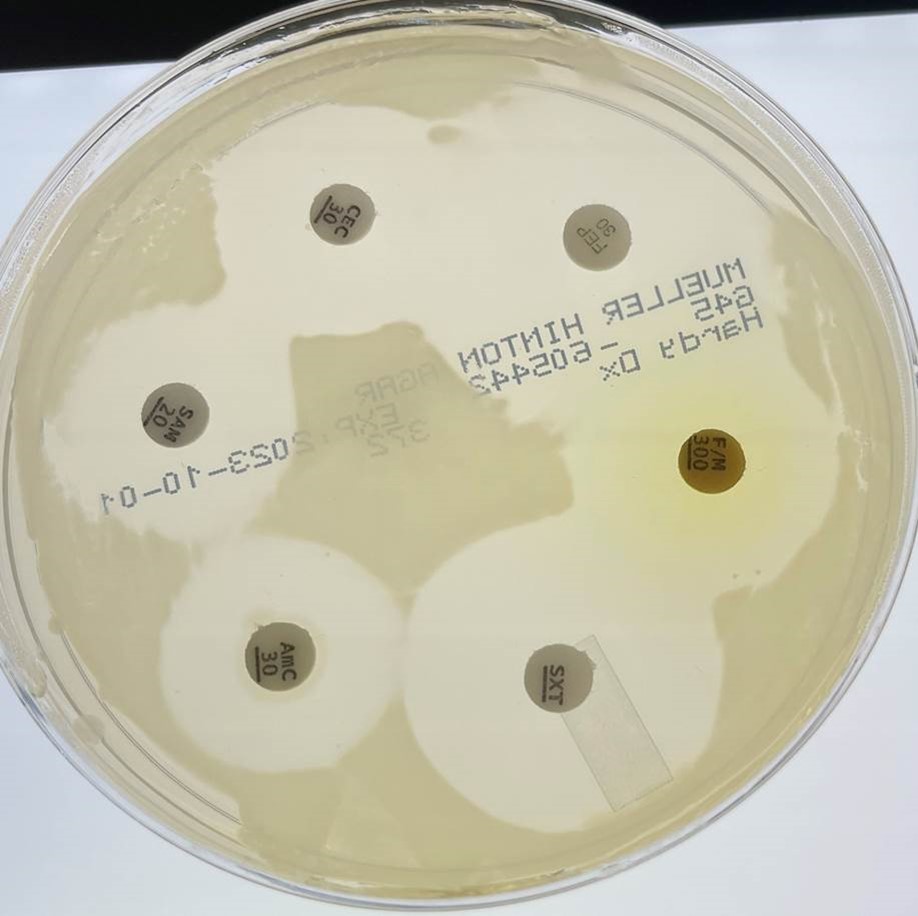

- Physician Advocacy -
Promoting the most effective treatments for patients that allows a medical practice to grow and flourish.

At VHS, we understand that running a medical practice can be a challenging task, with physicians often having to balance patient care with the business and financial aspects of running a practice. That’s why we offer a range of services to help physicians achieve their goals while staying on top of the latest medical technology.

- Lab Services -
We’re excited to announce that VHS is now a proud distributor for CirrusDx!
Through our alliance with CirrusDx, VHS now offers access to a full range of infectious disease testing services tailored to the needs of healthcare providers. CirrusDx’s state-of-the-art lab uses cutting-edge molecular diagnostics to deliver fast and accurate results, helping providers make informed decisions and improve patient outcomes. The process is designed for convenience — with sample collection available through secure shipping and quick turnaround times.
We strongly believe this allows us to provide even more comprehensive diagnostic support to healthcare providers, helping them deliver timely and effective care to their patients.
What Is Unique About Our New Testing Services:
PolyMic™ is CirrusDx’s antimicrobial susceptibility testing platform that provides tailored guidance on effective therapy by determining the specific antibiotic susceptibility for pathogens identified in patient samples, facilitating informed treatment decisions and improved patient outcomes
CirrusDx integrates its PolyMIC™, into several of its diagnostic panels such as:
Urinary Tract Infection Panel (UTIP™): Combines precise pathogen identification with polyMIC™ to determine the most effective antibiotics for treatment.
Aerobic Vaginitis Infection Panel (AVIP™): Utilizes PolyMIC™ alongside pathogen identification to offer actionable insights for effective treatment of aerobic vaginitis.
Wound Infection Panel (WIP™): Employs PolyMIC™ to provide comprehensive reports detailing pathogen identification and antibiotic susceptibility profiles, enabling targeted and effective treatment decisions.
A Sample of Testing Services Available:
-
UTIP™ (Urinary Tract Infection Panel)
-
AVIP™ (Aerobic Vaginitis Infection Panel)
-
BV/CV (Bacterial Vaginosis/Candida Vaginitis)
-
STIP™ (Sexually Transmitted Infection Panel)
-
Respiratory Infection Panel
-
Sexually Transmitted Infection Lesion Panel
-
WIP™ (Wound Infection Panel)
The CirrusDx Difference:
- No Inconclusive reports - ALL pathogens reported.
- No "Clean Catch" required.
- 27 different antibiotics tested at the same time.
- Negative Reports provided the same day as receipt.
- Positive Reports within 24 hrs. of receipt. (other than wound testing)

- Services for Diabetes Management -
Innovative Care for Managing Diabetic Neuropathy and Beyond.
At VHS, we understand that managing diabetes can be challenging. That’s why we offer a range of products and services to support physicians in their practice of treating diabetes. Our team is proud to provide a variety of cutting-edge medical devices to assist in diabetes management, such as the NeuroSolutions 100 NS100 device.

NeuroSolutions 100 and the NS100 device.
At VHS, we understand that managing diabetes can be challenging. That’s why we offer a range of products and services to support physicians in their practice of treating diabetes. Our team is proud to provide a variety of cutting-edge medical devices to assist in diabetes management, such as the NeuroSolutions 100 NS100 device.
The NS100 is a PNS/PENS device that sends impulses through electrode arrays that are programmed by a Programmable Technical Unit (PTU) based on the the diagnosis, and implanted directly into specific nerve endings in the ear.
The NS100 has proven to be very effective and safe for the treatment of chronic pain associated with diabetic neuropathy. * (Based on scientific evidence.)

Empowering Care Through Accurate Data Collection.
We also offer remote glucose monitoring patches that allow patients to monitor their glucose levels in real-time. This technology enables physicians to make more informed treatment decisions and can help reduce the risk of hypoglycemia and other complications.

Healing Starts Here – Advanced Wound Care Solutions.
Our team also specializes in diabetic wound care treatments. These innovative synthetic skin products help improve healing time and reduce the risk of complications associated with diabetic ulcers and wounds. When combined with proper wound testing lab services, you are armed with the most comprehensive data and treatment capabilities possible.
